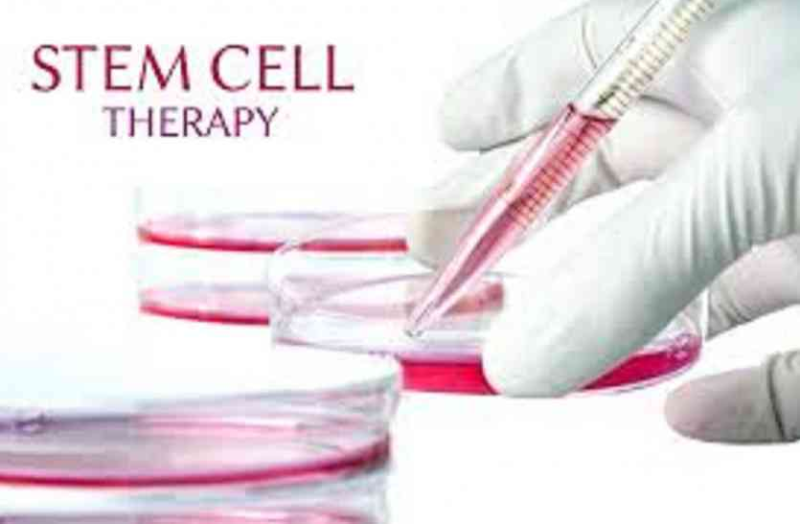

कैंसर, दिल संबंधी बीमारियां, स्ट्रोक, डायबिटीज, रीढ़ की हड्डी में चोट, मांसपेशियों में गड़बड़ी, लिवर व किडनी की बीमारी और आंखों की रोशनी चले जाना जैसी बीमारियों का इलाज किया जा सकता है।
हमारा शरीर कई कोशिकाओं से बना है और इसी वजह से ताउम्र शरीर में कई कोशिकाएं बनती या खत्म होती रहती हैं। स्टेम सेल थैरेपी एक ऐसी विधि है जिसमें शरीर की क्षतिग्रस्त कोशिकाएं दोबारा बन जाती हैं। स्टेम सेल हमारे शरीर की ही बुनियादी कोशिकाएं हैं, जिनमें कई तरह की दूसरी कोशिकाएं विकसित की जाती हैं। इस तकनीक में स्टेम सेल रोगी के ही रक्त या अस्थि मज्जा (बोन मैरो) से लिए जाते हैं और क्षतिग्रस्त जगह पर इन्हें रोपित किया जाता है जिससे चोटिल या क्षतिग्रस्त अंग में ये नई कोशिकाएं बनाने लगते हैं और चोट या क्षतिग्रस्त जगह ठीक होने लगती है। नाड़ी, मांसपेशी और रक्त कोशिकाओं का सीमित जीवनकाल होता है और ये खुद कई गुणा नहीं बन सकती लेकिन स्टेम सेल ये कोशिकाएं बन सकती हैं।
यहां से मिलेंगे स्टेम सेल -
स्टेम सेल को तीन तरह से प्राप्त किया जाता है। एक-गर्भस्थ शिशु के भ्रूण के तंतुओं से, जिसे भ्रूण स्टेम सेल कहते हैं। दूसरा, कार्ड स्टेम सेल जो कि जन्म के समय बच्चों के गर्भनाल से लिए जाते हैं। तीसरा, वयस्क स्टेम सेल जो बोनमैरो से एकत्र किए जाते हैं।
इनका हो सकता है इलाज -
कैंसर, दिल संबंधी बीमारियां, स्ट्रोक, डायबिटीज, रीढ़ की हड्डी में चोट, मांसपेशियों में गड़बड़ी, लिवर व किडनी की बीमारी और आंखों की रोशनी चले जाना जैसी बीमारियों का इलाज किया जा सकता है।
थैरेपी के फायदे -
ह्रदय की मांसपेशियों और ऊतकों का नवीकरण नहीं हो सकता। एक बार अगर ये क्षतिग्रस्त हो गए तो स्थायी रूप से खत्म हो जाते हैं लेकिन अब स्टेम सेल तकनीक द्वारा इन ऊतकों और मांसपेशियों को दोबारा पुनर्जीवित किया जा सकता है। वैसे इस थैरेपी का कोई दुष्प्रभाव भी नहीं है।
Published on:
04 Nov 2018 05:55 pm
बड़ी खबरें
View Allरोग और उपचार
स्वास्थ्य
ट्रेंडिंग
लाइफस्टाइल
